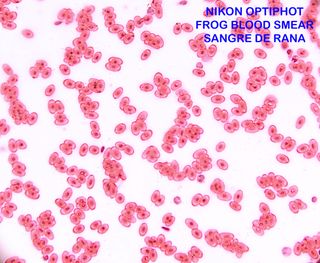

Microscopio de segunda mano Madrid
Sugerencias para ti
Novedades
Microscopio Educativo Infantil
Microscopio diseñado para niños, con un colorido y atractivo formato. Microscopio Digital para Niños con Pantalla IPS de 2.0'', Recargable 1000x, Electrónico con 8 Luces LED. - Incluye cinta para colgar. - Cable de carga USB.
Microscopio PIERRON XSP-02
Microscopio PIERRON modelo XSP-02 Ideal para estudiar, investigar y experimentar. Fácil de uso. Perfectamente apto para niños, jóvenes y adultos. Muy educativo. - Cuerpo metálico y base de herradura. Muy sólido y estable. - Enfocador micrométrico de precisión. - Dos oculares 10x y 15x. - Tres objetivos 4,10 y 40x. - Aumentos 40,60,100,150,400,600x - Lámpara con luz LED regulable - 5 portaobjetos + 3 preparado Las últimas fotos se han hecho con el móvil directamente en el ocular.
Microscopio Binocular Carl Zeiss
Microscopio binocular CARL ZEISS. Ideal para estudiar, investigar y experimentar. Muy fácil de usar. Muy robusto. Irrompible. Perfecto para niños, jóvenes y adultos. Muy educativo. - Cuerpo metálico. Muy sólido y estable - Enfocador micrométrico de precisión - Platina giratoria - Condensador con diafragma. - Objetivos ZEISS: 8,20,40,90x - Dos oculares CBS 10xPK - Aumentos: 80x,200x,400x,900x - Lámpara con luz LED regulable - 5 portaobjetos + 3 preparado Las últimas fotos se han hecho con el móvil directamente en el ocular.
Microscopio Binocular PANAGOR con caja
Microscopio binocular de la marca PANAGOR con caja de madera. Ideal para estudiar, investigar y experimentar. Muy fácil de usar. Muy robusto. Irrompible. Perfecto para niños, jóvenes y adultos. Muy educativo. - Cuerpo metálico. Muy sólido y estable - Enfocador micrométrico de precisión. - Platina micrométrica - 3 objetivos: 10,40,100x - Oculares WF16x - Aumentos: 160,640 y 1600x - Condensador con diafragma - Caja de madera con llaves Las últimas fotos son de un ala de insecto y se han hecho con el móvil puesto directamente en el ocular.
Microscopio LED 45X
#NO REGATEO PRECIOS# Bloqueo chat con "ofertas" y regateos, gracias. DESCRIPCIÓN: Microscopio de gran aumento de 45X y luz LED y ultravioleta integrada. Ideal para observar detalles pequeños como estrellas en monedas o similares. Pila NO incluida. Se ha usado muy poco, costó el doble. PRECIO: 3€ -FIJOS NO NEGOCIABLES- ENVIO: - Ordinario: 1-2€ según peso - Certificado: 6-7€ según peso - Wallapop: Solo si es compra mínima de 30€ SE PUEDEN AGRUPAR ARTICULOS
Microscopio estereoscópico de hasta 90 aumentos
Microscopio o lupa binocular estereoscópica con zoom. Aumenta entre 7 y 40 veces con sus oculares de 10x; la mitad de ese intervalo con la lente Barlow de 0,5x o el doble con la de 2x. Sirve para electrónica, entomología, filatelia, numismática, etc. Aparato fácil de usar y que funciona como nuevo. Luces led y oculares Zeiss 6x aparte. Puedo enviarlo perfectamente en su embalaje original.
Microscopio Euromex MB.1153 Negociable
- Solo se ha abierto para comprobar que esté todo. - La primera foto es del mismo modelo - Es pequeñito, perfecto para instituto o laboratorio en casa. - Viene con pilas recargables por si no quieres estar todo el rato con el cable, se puede usar con cable sin las pilas puestas. - También viene con su funda de plástico y aceite de inmersión.
Microscopio Lomo MBR-1
Microscopio soviético marca Lomo modelo MBR-1, años 60’. Excelente microscopio, muy bien conservado. Tiene marcas de uso pero está en muy buenas condiciones. Ha sido revisado y engrasado. Los enfoques (macro y micro) funcionan muy bien. Tiene la mesa redonda que gira y una platina marca Lomo, años 60’, en perfecto funcionamiento. Tiene 4 objetivos acromáticos: 8x, 20x, 40x y 90x de inmersión en aceite. 3 oculares de compensación (mejoran la visión de los objetivos acromáticos) K7x, K12,5x y K16x. Aumentos de 56x a 1440x máximo. La caja es la original, restaurada y con llave. IIuminación con espejo y luz led.
Microscopio binocular Nikon (Nippon Kogaku)
Fabricado en Japón hacde 70 años, todo original Nikon (= Nippon Kogaku) excepto la iluminación, que es un led moderno de 5W a 12V. Precioso y funcional, en muy buen estado estético, óptico y mecánico. Con los oculares de 10x aumenta 40, 100, 400 o 1000 veces. El condensador es más sencillo de regular que el de microscopios posteriores. Mesa X-Y y giratoria. Para exponer y para seguir usando muchos años. Precio con el cabezal binocular, como en la primera foto; por 25 € añadiría un cabezal monocular con un ocular de 5x y filtro, accesorios recomendables para sacar fotos.
Microscopio Reichert Jung con Fluorescencia
Microscopio binocular marca Reichert Jung con equipo de Fluorescencia integrado. - Marca: Reichert Jung. - En buen estado, necesita limpieza.
Microscopio TIGER para niños
Microscopio infantil de la marca TIGER. Diseñado para ser fácil de usar y atractivo para los más pequeños. - Incluye portaobjetos y cubre objetos e instrucciones - Diseño robusto y seguro.
Carl Zeiss Objetivo Microscopio 3,2X
Objetivo para microscopio de la marca Carl Zeiss. - Magnificación: 3,2x. - Perfectas condiciones. NIKON, CARL ZEISS, OLYMPUS, AMSCOPE, LEITZ, MEIJI, LABOMED, LEICA, EUROMEX, MOTIC, OPTIKA, REICHERT, PZO, PARCO, LOMO, BRUKER, ACCU-SCOPE.
Fototubo Leitz Wetzlar 1.25x microscopio
Sólo fototubo de la marca Ernest Leitz Wetzlar. - Diámetro interior: 44 mm. - Diámetro exterior: 50 mm. - Ampliación: 1.25x. NIKON, CARL ZEISS, OLYMPUS, AMSCOPE, LEITZ, MEIJI, LABOMED, LEICA, EUROMEX, MOTIC, OPTIKA, REICHERT, PZO, PARCO, LOMO, BRUKER, ACCU-SCOPE.
Microscopio Bresser Biolux NG 40x-1024x
Microscopio Bresser Biolux NG con aumento de 40x a 1024x. Incluye ocular para PC. - Aumento: 40x-1024x - Incluye PC-Ocular - Marca: Bresser
Microscopio Digital Portátil Amarillo
Totalmente nuevo sin abrir . Microscopio digital portátil de color amarillo, ideal para observar detalles de hojas, insectos y otros elementos pequeños. Incluye accesorios para su uso. - Pantalla integrada. - Diseño ergonómico. - Incluye pinzas y soporte.
CABEZAL BINOCULAR MICROSCOPIO
Cabezal binocular para microscopio. - Diseño robusto y duradero. NIKON, CARL ZEISS, OLYMPUS, AMSCOPE, LEITZ, MEIJI, LABOMED, LEICA, EUROMEX, MOTIC, OPTIKA, REICHERT, PZO, PARCO, LOMO, BRUKER, ACCU-SCOPE.
Microscopio Digital PARALUX con pantalla LCD
Microscopio digital de la marca PARALUX con pantalla LCD integrada. SIN USAR Fue un regalo con poco acierto ya que no se ha usado nunca!! Tiene algunas muestras ya preparadas como se ve en la imagen de la pata de mosca. Con si bola para transportar y accesorios. Pantalla LCD de 3.5 pulgadas. Ampliaciones de 40X y 400X. Incluye 3 oculares. Cámara de 2 Megapíxeles. Conexión USB.
Microscopio estereoscópico Seben Incógnita III
Incluye: -tres juegos de oculares 10x, 20x y 25x -Lente de aumento 2x y 4x. Hasta 100 aumentos. -Luz transmitida (diascópica) y reflejada (episcópica). -Luz y fusible de repuesto. -Placa translúcida para luz transmitida. -Placa blanca/negra para luz reflejada. -Con maleta a medida.
Set Microscopio IXPLO 100x-1200x 55 piezas
Set de microscopio IXPLO con 55 piezas. - Zoom de 100x a 1200x. - Incluye accesorios para empezar a explorar.
Portaobjetos microscopio y triquinoscopio
Set de portaobjetos para muestras de microscopio y triquinoscopio. - Incluye varios portaobjetos de vidrio. - Diseñados para su uso en laboratorios o estudios científicos. Analistas,veterinarios,cultivos organicos,triquinosis. Algunos sin estrenar
Microscopio 900x y Telescopio Discovery Channel
🔬🔭 Set educativo original de Discovery Channel, ideal para niños curiosos y amantes de la ciencia. Incluye microscopio con hasta 900x de aumento y telescopio, además de múltiples accesorios para experimentar y aprender. 📦 Contenido del kit: • Microscopio hasta 900x • Telescopio • Portaobjetos y accesorios • Herramientas de observación • Manual de instrucciones ✨ Estado: Nuevo / sin usar (precintado o tal como se ve en las fotos).
Microscopio AmScope Monocular WF25X
Microscopio AmScope monocular sin uso. - Cuerpo blanco y negro. - Base gris con perillas de enfoque. - Número de serie: 1801332. No incluye caja. Incluyo Cubrecubiertas AmScope 22×22 mm (100 pcs) Precio no negociable
Microscopio Digital USB
Microscopio digital con sensor CMOS a color y DSP de alta velocidad. Funciona con conexión USB 2.0 y USB 1.1.Se puede ver en el PC,Tablet o teléfono Android... - Resolución 640x480. - Compatible con USB 2.0 y USB 1.1. - Incluye CD con software. EN SU CAJA ORIGINAL.... NO ENVÍO
Microscopio Miniland 640x Educational
Microscopio Miniland Educational 640x Esta casi sin usar. - Incluye: Manual de instrucciones, muestras, microscopio, utensilios varios, y lentes.
Microscopio educativo
Microscopio educativo en su caja original, ideal para iniciarse en el mundo de la ciencia. - Diseño clásico en color negro. - Incluye accesorios y manual. - Presentado en un estuche protector.
Precio por conversar.. microscopio negro Kenko
Microscopio óptico de color negro, ideal para observaciones detalladas. Su diseño clásico lo hace un equipo funcional. - Cuerpo metálico. - Base estable. - Brazo curvo para ajuste.
Microscopio Euromex StereoBlue + Cámara Amscope
Vendo microscopio estereoscópico Euromex StereoBlue, muy fiable y con una calidad óptica excepcional, ideal para electrónica (SMD), inspección de placas, mineralogía, biología, restauración y proyectos profesionales o educativos. El equipo está muy bien cuidado, funciona perfectamente y se entrega con todos sus accesorios originales, además de una cámara digital Amscope MU300.
Set Microscopio con Accesorios
Set de microscopio completo, ideal para iniciarse en la ciencia. Incluye varios accesorios para su uso. - Microscopio de color azul. - Estuche para transporte y almacenamiento. - Incluye portaobjetos, tubos de ensayo y otros elementos. - Diseñado para facilitar el aprendizaje y la exploración.
Oculares Zeiss 12,5x para microscopio
Pareja de oculares Zeiss de 12,5 aumentos para microscopios quirúrgicos (OPMI) y biomédicos modernos. Son buenos de fábrica, están impecables y tienen dos características poco corrientes: guardas de goma enroscables y una palanquita que sujeta el ajuste de dioptrías. El diámetro de inserción es 25 mm o 30 mm con tubos adaptadores. He probado estos oculares en un microscopio biomédico Leica DMLB y en un estereomicroscopio y funcionan muy bien en los dos.
Microscopio National Geographic 900x
Microscopio National Geographic con aumento de 900x, ideal para explorar el mundo.Usado una vez con todos los utensilios que vienen en el pack.Parece nuevo.Todo el pack completo.Hago envios y trato en mano cerca de mi. - Incluye criadero de especímenes. - Incluye portas y cubreobjetos. - Maletín de transporte.
Microscopio con Maletín y Accesorios.
Microscopio compacto guardado en su maletí metálico. Con distintas lentes de aumento. Incluye materiales para la preparación de muestras y manual de instrucciones. Perfecto para ser transportado.
Microscopio infantil Futuros Genios
Kit de microscopio Futuros Genios para los más pequeños. Incluye todo lo necesario para iniciarse en el mundo de la ciencia. - Microscopio azul. - Lupa de aumento. - Muestras de pelo animal. - Portaobjetos. - Tubos de ensayo y recipientes para muestras.
Microscopio Nikon S-Kt
Microscopio óptico hecho en Japón hacia 1975. Completo, limpísimo y en muy buen estado aparente y funcional; bien podrá servir otros cincuenta años a cualquier médico, veterinario, o biólogo profesional. Par de oculares HK 5x (otro par Nikon CFWE 10x por 30 € más), 5 objetivos. Modelo SBR-Kt: Standard (S), cabezal binocular inclinado 45° (B), pletina con movimientos ortogonales y giratorio (R), iluminación regulable de 0 a 6 V según Köhler (Kt), dos bombillas de repuesto, funda de plástico, caja de madera a medida con llave. Todo Nikon original de gran calidad. Cámara digital, 30€.
Microscopio Buki France con accesorios
Microscopio educativo Buki France, ideal para iniciarse en el mundo de la ciencia. Incluye varios accesorios para la observación. - Microscopio con objetivos 10x. - Pinzas, bisturí y aguja. - Portaobjetos preparados (algas, hongos, etc.). - Tubos de ensayo y lupa. - Caja de 12 portaobjetos.
LENTE MONOCULAR ZOOM 8,5:1 IND. DIGITAL CAM CMOUNT
LENTE MICROSCOPIO MONOCULAR ZOOM 8,5:1 INDUSTRIAL PARA CÁMARA MICROSCOPIO DIGITAL CMOUNT - Diámetro: 40mm y 55 mm - Peso: 600 gramos - Longitud: 165 mm - Rango distancia de trabajo: 11 mm a 12 mm - Utilizada en inspección industrial, soldadura de precisión y reparación electrónica. - Diseñada para usarse con cámaras industriales o de microscopía. - Zoom de de rango medio-alto 8,5:1 (Objetivo versatil con capacidad de aumento variable desde la distancia focal máxima 8,5 veces a la distancia focal mínima. - En la mínima aumento de 21X - En la máxima aumento de 180X
Microscopio 10x-1200X Óptica Precisión
Microscopio de óptica de precisión con aumentos de 10x a 1200x. Incluidos accesorios para iniciarse en la observación. +10 años. Incluye luz. Bombilla funcionando. Base metálica, muchos accesorios. No incluidas las pilas. - Cuerpo metálico plateado. - Base estable. - Incluye portaobjetos y viales.
Microscopio Biológico Enosa
Microscopio biológico de la marca Enosa. Se recoge en persona en Alcalá de Henares ( Madrid) - Diseño compacto y portátil. - Cuerpo principal en color blanco. - Incluye enfoque y ajuste de magnificación. -Funciona con luz natural
Microscopio biomédico Zeiss Axioskop
Microscopio óptico pensado para uso diario en laboratorios biológicos, médicos o veterinarios; es ideal para anatomopatólogos. Cuatro objetivos Plan Neofluar (plan-acromáticos y aptos para fluorescencia, excelentes), otro Achroplan 100x (bueno también) y queda un hueco en el carrusel para un 6º objetivo. Un par de oculares Zeiss de 12,5x, 10x o 6x a elegir. Condensador con lente basculante. Lámpara regulable de 0 a 12V con bombilla halógena Osram de 50W y otra de reserva led o halógena. Pesa 11 kg. Lentes limpias. Todo Zeiss y funcionando bien. Animo a examinar el microscopio junto conmigo antes de pagarlo y llevárselo.
ZEISS CABEZAL + ANGULAR + CONDENSADOR
Conjunto de componentes ópticos ZEISS. Microscopio Carl Zeiss, Cabezal, Tubo angular Pol-d, factor 2x, Condensador de luz incidente y compensador lambda/4 . Diseñado para microscopía. Este es el condensador de luz reflejada polarizada para los modelos Amplival, Mikroval, Ergaval, Laboval, etc. Con varilla de tracción delantera para mover el analizador. Los deslizadores con valores lambda o un cuarto de lambda se introducen en el eje, q puede girar 45°. - Cabezal. - Pieza angular. - Condensador. - Compensador. NIKON, CARL ZEISS, OLYMPUS, AMSCOPE, LEITZ, MEIJI, LABOMED, LEICA, EUROMEX, MOTIC, OPT
Portaobjetos microscopio Labbox 50 uds
Caja de portaobjetos para microscopio de la marca Labbox. - Modelo: SLIF-010-050 - Medidas: 26 x 76 mm - Bordes pulidos y esquinas cortadas a 45° - Superficie esmerilada simple - Incluye 50 portaobjetos
Set Microscopio 28 Piezas 1200X
Set de microscopio de 28 piezas con hasta 1200X de aumento. Incluye accesorios para empezar a explorar. - Incluye 5 portaobjetos preparados y 7 portaobjetos en blanco. - Incluye criadero de camarones, cortador de especímenes y portaobjetos. - Incluye placa de Petri. - Construcción duradera de metal. Nos costó 125 euros
Microscopio H10X para niños
Microscopio educativo con aumento de 400x. - Lente ocular H10X. - Objetivos: 4X, 10X, 40X. - Ampliaciones totales: 40X, 100X, 400X.
Microscopio Bausch & Lomb StereoZoom 4
Microscopio estereoscópico fabricado en los Estados Unidos hacia 1970. Todo original, salvo los oculares "genéricos" de 10x o los Nikon de 10x (por 20€ más) y el led con disipador y regulador de intensidad. Hace zoom continuo al girar la rueda de arriba, entre 7 y 30 aumentos. Aparato de buena calidad, documentado (en inglés) y en muy buen estado óptico, mecánico y estético. Modelo profesional, muy conocido en América. Listo para usar por cualquiera de 8 años para arriba. Ideal para manipular relojes, insectos vivos, monedas, hongos, manchas en la ropa, pintar miniaturas, etc. Lo enseño con gusto. Precio fijo.
Microscopio Edu Science 450x
Microscopio Edu Science con aumento de 450x. - Incluye 2 portaobjetos preparados. - Incluye 2 portaobjetos en blanco. - Iluminación LED.
Microscopio Kosmos My Discovery
Microscopio de biología Kosmos para jóvenes investigadores. Permite hasta 600x de magnificación. - Incluye herramientas de preparación. - Luz LED de larga duración.
Caja Portaobjetos Microscopio ME-1
Caja de portaobjetos preparados para microscopio. - Modelo: ME-1 - Contenido: Fibras textiles - Ideal para estudiantes de ciencias.
CARL ZEISS CONDENSADOR LUZ INCIDENTE + COMPENSADOR
Condensador de luz incidente mas compensador para microscopio Carl Zeiss. Diseñado para microscopía. Este es el condensador de luz reflejada polarizada para los modelos Amplival, Mikroval, Ergaval, Laboval, etc. Con varilla de tracción delantera para mover el analizador. Los deslizadores con valores lambda o un cuarto de lambda se introducen en el eje, q puede girar 45°. - Componente óptico de precisión de Carl Zeiss. NIKON, ZEISS, OLYMPUS, AMSCOPE, LEITZ, MEIJI, LABOMED, LEICA, EUROMEX, MOTIC, OPTIKA, REICHERT, PZO.
Iluminador Carl Zeiss H-Pl-Pol + RATHENOW 100X
Iluminador Microscopio Carl Zeiss H-Pl-Pol fabricado en Alemania Occidental. Iluminador Carl Zeiss H-Pl-Pol con un objetivo Rathenow cuyo mayor accionista era Carl Zeiss - Modelo: H-Pl-Pol - Marca: Carl Zeiss - Fabricado en: West Germany - Incluye accesorio RATHENOW 100X Pol v NIKON, CARL ZEISS, OLYMPUS, AMSCOPE, LEITZ, MEIJI, LABOMED, LEICA, EUROMEX, MOTIC, OPT
Microscopio Carrefour Explorer
Microscopio Carrefour Explorer, prácticamente nuevo. Ideal para jóvenes científicos. - Incluye estuche de transporte. - Microscopio con varios lentes. - Accesorios para experimentos. Nota. Ha sido poco usado, tiene tofos los componentes, etiquetas sin usar, muestras, recoge muestras...
Atlas Temático Microscopía
Atlas Temático Microscopía en perfecto estado. Ideal para estudiantes o aficionados a la microscopía. - Incluye ilustraciones detalladas de microscopios y herramientas. - Perfecto para aprender sobre microscopía. - Actualmente agotado. Difícil de encontrar
Microscopio Bolsillo 60x
Microscopio de bolsillo 60x. Se encuentra en buen estado y se entrega con su estuche protector. - Aumento de 60x. - Incluye estuche.
Microscopio Deluxe 48 piezas
Microscopio Deluxe de 48 piezas en perfecto estado. Incluye estuche de transporte. - Microscopio con aumento. - 48 piezas para explorar el mundo microscópico. - Ideal para principiantes.
Oculares Zeiss 10x/20 para microscopio
Dos oculares marca Carl Zeiss para microscopios con tubos de 30 mm de diámetro. Uno es E-Pl 10x/20 (45€) y el otro es Pl 10x/20 (40€). Ambos en muy buen estado, con ligeras marcas de uso en el plástico. Los vendo sueltos, o juntos por 75€ porque no hacen la pareja que me vendría bien tener para un Zeiss Axioskop, que vendo aparte. Alternativamente, yo compraría un ocular que emparejara bien con uno de los dos de este anuncio.
TUBOS ACCESORIOS MICROSCOPIOS
PRECIO POR UNIDAD DEPENDIENDO EL QUE SE ESCOJA (ALGUNOS A 5€). VARIOS TUBOS ACCESORIOS MICROSCOPIO TELESCOPIO PREGUNTAR MEDIDAS DIFERENTES PRECIOS. NIKON, CARL ZEISS, OLYMPUS, AMSCOPE, LEITZ, MEIJI, LABOMED, LEICA, EUROMEX, MOTIC, OPTIKA, REICHERT, PZO, PARCO, LOMO, BRUKER, ACCU-SCOPE.
MICROSCOPIO INFANTIL CON ACCESORIOS
Microscopio científico para niños, en perfecto estado. Incluye 62 piezas. - Aumentos de 100x, 600x y 1200x. - Lentes de cristal óptico para una precisión magnífica. - Soporte de metal resistente y duradero. - Ideal para despertar la curiosidad científica.La caja tiene alguna señal de uso
Laminas de Microscopio para niños (2 uds)
precio original (amazon) - 2 cajas por 5,89 2 cajas (24 láminas por 3,50€) 1 caja (12 láminas por 2,50€) 12 cuchillas de microscopio con especímenes para niños, láminas de microscopio preparadas con plantas, animales e insectos, cuchillas de microscopio para adultos, niños, estudiantes, escuela en casa, ciencia, stem, investigar, aprender jugando
Microscopio infantil
Microscopio infantil con maletín, accesorios y manual de instrucciones.
Microscopio set
Set microscopio infantil
40X PZO OBJETIVO MICROSCOPIO
OBJETIVO PARA MICROSCOPIO MARCA PZO 40X EN BUEN ESTADO NIKON, ZEISS, OLYMPUS, AMSCOPE, LEITZ, MEIJI, LABOMED, LEICA, EUROMEX, MOTIC, OPTIKA.REICHERT, PZO.

Microscopio
microscopio antiguo de metal
Microscopio
Microscopio, la caja está un poco rota pero el microscopio funciona a la perfección.
Microscopio infantil
Microscopio infantil para iniciarse en la ciencia. - Diseño compacto y fácil de usar. - Incluye base y brazo para sujeción. - Lente de aumento. - Compartimento para muestras.
Set Microscopio 28 Piezas 1200X
Set de microscopio de 28 piezas con aumentos de hasta 1200X. Incluye accesorios para empezar a explorar. - Incluye 5 portaobjetos preparados y 7 portaobjetos en blanco. - Contiene Shrimp Hatchery para cultivar camarones. - Incluye Petri Dish (plato de cultivo). - Construcción duradera de metal. Regalo cuatro bandejas de pruebas para mirar bajo el microscopio.
Microscopio x100 x450 x900
Microscopio básico para niños, con led, 3 objetivos y portaobjetos/ botes para muestras
Kit Bresser Junior Telescopio y Microscopio
Conjunto de iniciación Bresser Junior que incluye un telescopio y un microscopio. - Telescopio con trípode y adaptador para móvil. - Microscopio con accesorios. - Ideal para jóvenes exploradores.
Microscopio Bresser Junior Biotar 300x-1200x
El microscopio BRESSER JUNIOR Biotar 300-1200x te ofrece un rápido inicio en el mundo del microscopio. Sus complementos incluidos te ofrecen el equipamiento básico perfecto. Hay muchas cosas para descubrir! Descúbrelo junto a tu nuevo microscopio. Podrás lograr tus primeras observaciones fácilmente ya que con este producto obtendrás todos los complementos necesarios para usar tu microscopio. ROPIEDADES Set de microscopio para principiantes Aumento: 300x-1200x Iluminación por pilas Amplio paquete de complementos para empezar ahora mismo
Microscopio Gemológico Gemolite Mark X
Microscopio gemológico Gemolite Mark X. (GIA) Gemological Institute of America. Laboratorio Gemologico de referencia internacional. - Modelo: Gemolite Mark X - Lentes: Leica - Tipo: Microscopio Gemologico - Identificación de gemas. - Análisis de inclusiones - Clasificación de diamantes. - Uso profesional. - Uso didáctico en centros de estudio Gemologico y para aficionados a las gemas.
Placa de polarización para microscopio
Placa de polarización para microscopio, con marcas de grados. - Diámetro exterior aproximado: 15 cm. - Mecanismo de ajuste con tornillos. - Metálica
Microscopio KONUS COLLEGE 600X
Microscopio KONUS COLLEGE con aumento de 600X. - Modelo: 5302. - Incluye oculares y accesorios. - Funciona perfectamente. Se vende por falta de uso
Objetivo Reflector CTS Microscopio
Objetivo reflector para microscopio de la marca Cooke Troughton & Simms. 40x COOKE-A.E.I. N.A. 0.57 D. 5293 PH. Gran ancho de banda Sin efectos cromáticos Gran distancia de trabajo
Microscopio metalográfico Cooke Troughton & Simms
Microscopio clásico de la marca Cooke Troughton & Simms. Un instrumento de precisión con un diseño robusto. -objetivos originales Cooke 45x, 40 y 10x Objetivo inmersión Vickers 100x Oculares originales Cooke 6x y 8x - Viene con su caja de madera original para almacenamiento.
Microscopio Tiger - Microscopio infantil
Microscopio para niños, en perfecto estado. Es un microscopio de juguete, ideal para despertar la curiosidad científica de los más pequeños. - Incluye varios portaobjetos. - Diseño compacto y ligero. - Marca Tiger.
Microscopio científico
Vendo microscopio científico en perfecto estado. - Incluye todos los accesorios necesarios para su uso. - Lente de alta calidad para una visualización nítida. - Diseño ligero y fácil de transportar.
Microscopio USB Visiomar: 20x & 200x
Microscopio USB Visiomar en buen estado. Ideal para observaciones detalladas. - Microscopio digital con conexión USB. - Aumentos de 20x y 200x. - Iluminación LED. - Incluye 2 pilas AA y portaobjetos. (No incluidas). Muestras varias y fotos de planetas incluidas como extra. Se conecta a ordenador para visionado. Incluye software.
Microscopio Digital Electronico Profesional
Microscopio digital electronico portatil profesional. Microscopio profesional le permite acercar y alejar para ver detalles increíbles en un rango de aumento de 50-1000X. Dispone de pantalla IPS HD de 4,3 pulgadas con imagen digital 1920x1080p. Tiene 8 luces LEDs para ajustar la iluminacion. Vista desde ordenador con imagen a tiempo real para realizar fotos y videos. Compatible con Windows y MacOS. Batería recargable de 2000 mAh. Compatible con tarjetas de memoria. Realizamos envios por Wallapop y envios contrareembolso. Producto nuevo con 2 años de garantia.
Microscopio Buki 30 experiencias
Microscopio Buki en buen estado, ideal para iniciarse en el mundo de la ciencia. Incluye 30 experiencias. - Ampliaciones: 100X, 600X, 1200X. - Edad recomendada: 8+ años. - Marca: Buki France Science.
Kit Científico Primeros Descubrimientos
Kit de ciencia para niños con todo lo necesario para las primeras exploraciones. - Incluye lupa, microscopio y recipientes. - Diseñado para fomentar la curiosidad y el aprendizaje. - Estuche portátil para fácil transporte. -el microscopio lo puedo vender aparte
Nioxin Nioscope 2.0 Mini-Microscopio
Mini-microscopio Nioscope 2.0 de Nioxin para análisis de cuero cabelludo y cabello con app para movil. Diseñado para ser compacto y fácil de usar. - Modelo: Nioscope 2.0 - Uso: Análisis de cuero cabelludo y cabello
Microscopio para niños
Microscopio, modelo m640x Edu Science.